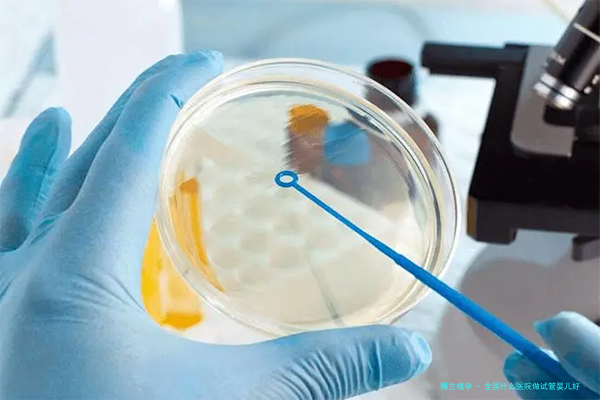

全国各大医院均有开展试管婴儿手术的本事,但是最专业、最安全的试管婴儿医院就几家了,它们具有强大的专业团队,完美的技术和设备等,其中有上海正东医院,北京凤凰医疗中心,武汉小儿医院,济南安和男子医院,南京仁衡医院等。
上海正东医院:在上海,正东医院是一家有着国际有声誉度的高端医疗机构,针对性激素异常和辅助生殖技术(ART),该院建立组建了一支资深专家团队,专业细化程度非常高,团队中有多年试管婴儿国际临床研究的医生,试管婴儿率比较高,有很好的临床经验,把每一例患者都当成特殊的实例,从治疗期间的养分等方向全方位认知病人,调整治疗方案,有利于提高生育比率。
北京凤凰医疗中心:北京凤凰医疗中心是一家全球最有影响力的医疗中心之一,多年来一贯专心于人类辅助生殖技术,其超过22年的临床数据及试管婴儿全国第一位成功率均处在全国优异状态,荣获中国卫生部颁发的“试管婴儿技术先进单位”称号,享有超群的规模和专业的器械,他们的设备和服务契合诊断质量标准,确确保品质量,是国内非常好的试管婴儿医院之一。
武汉小儿医院:武汉小儿医院是中国卫生部资深医院,提供品质高
全国甚么医院做试管婴儿好?现在国内试管婴儿技术水准较高的医院有:北京老字号医院试管婴儿中心,上海试管助孕医院医药学专业归属的第九助孕医院试管婴儿中心,浙江大学所属1级医院试管婴儿中心,深圳市第二助孕医院试管婴儿中心等。
北京老字号医院试管婴儿中心,起首成立于1986年,是中国第一个把试管出生作为常规服务提供应病人的医院___,开辟了中国试管婴儿技术的浓厚历史。北京老字号医院试管婴儿中心是国内试管婴儿基地之一,具有优良的医疗器械和专业的医护人员,具有优良的诺言和抗拒胎儿死亡率低的优势,在成功率方面表现优异,可谓国内试管婴儿技术的佼佼者。
上海试管助孕医院医药学专业所属第九助孕医院试管婴儿中心,拥有专业的试管婴儿集体和前沿的试管婴儿技术,能够提供优良的试管婴儿服务。此外之外,它还享有出色的婴儿麻木医生,可以确保试管婴儿全程无酸麻。该中心以及出色的试管婴儿大夫团队,可以为家庭提供多介入、精密、安全、高效能的试管婴儿技术,确保试管婴儿的成功率。
浙江大学从属的1级医院试管婴儿中心,该中心作为一家国家三甲医院,享有良好的保护人员,完善的医疗设
转载请注明出处。